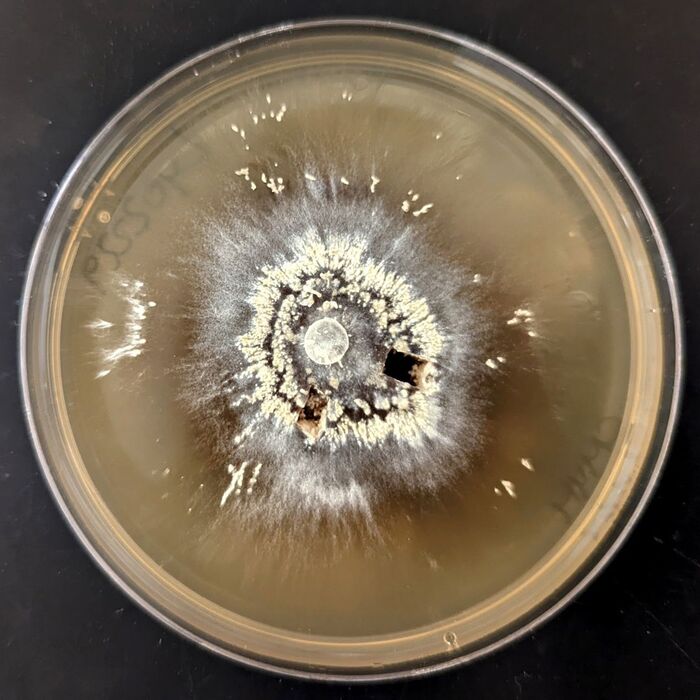
. 2)

Две страны должны отбросить недоверие, чтобы установить правила мирного использования космического пространства.
В наши дни Китай, несомненно, является одним из ведущих мировых игроков в космос, с успешными миссиями на Луну и Марс и солнечным зондом, который должен быть запущен в ближайшее время. Его подъем подстегнул конкуренцию с США; « Следите за китайцами », — недавно предупредил администратор НАСА Билл Нельсон. Учитывая стратегическую ценность, которую две страны придают своим космическим программам, и политическую напряженность, которая уже существует между странами, борьба за достижения в космосе, вероятно, обострится.
Несмотря на напряженность, США и Китай должны найти способ сотрудничать по некоторым, если не по всем, вопросам использования космоса. Наиболее важной областью является безопасность космической инфраструктуры, где отсутствие связи может быть разрушительным и, возможно, даже смертельным. Эта необходимость была подчеркнута недавней сагой о близком столкновении между двумя спутниками Starlink Илона Маска и китайской пилотируемой космической станцией. Хотя космические корабли Starlink находятся в частной собственности, правительство США несет международную ответственность за их космическую деятельность в соответствии с Договором о космосе 1967 года.